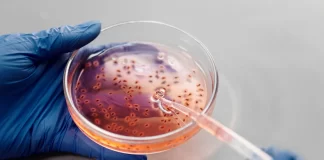
Interesting Fun Facts about DNA Interesting Fun Facts about DNA provides fun and interesting facts about the history of yourself, life and anything else that has the potential for intrigue.

ReferSMS offers the latest news on technology, business, sports, travel, parenting, health, and more. Stay informed with up-to-date information and insights across all your favorite topics.
Contact us: contact@refersms.com
© ReferSMS 2016 - 2024, All Rights Reserved